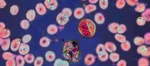
Esto sabemos de la misteriosa enfermedad en RDC

Personal de la Secretaría de Seguridad Pública de Sinaloa, a través del Grupo Élite de la Policía Estatal Preventiva, en coordinación con la Secretaría de la Defensa Nacional, la Guardia Nacional, la Secretaría de Marina, la Fiscalía General de la República y la Fiscalía General del Estado, aseguró camionetas con reporte de robo reciente, armas largas, municiones y equipo táctico.

Derivado de trabajos de reconocimiento y seguridad en la colonia 4 de Marzo de la sindicatura Villa Juárez, en Navolato, los policías estatales del Grupo Élite localizaron lo siguiente:
– 1 camioneta marca Ford Ranger con reporte de robo del 27 de febrero de 2025.
– 1 camioneta marca Renault, modelo 2024, con reporte de robo.
– 1 camioneta marca Nissan, modelo 2024, con reporte de robo del 27 de febrero de 2025.
En el interior de dichos vehículos se localizó el siguiente armamento:
– 3 fusiles tipo AK-47, calibre 7.62 x 39 milímetros, con cargadores abastecidos.
– 1 fusil M16, calibre 5.56 milímetros, con cargador abastecido.
– 2 chalecos porta cargadores, cada uno con 4 cargadores para fusil AK-47 abastecidos.
– 1 cartuchera con 3 cargadores abastecidos con cartuchos de 7.62 x 39 milímetros.
– 16 cargadores para fusil AK-47 abastecidos.
– 7 cargadores para fusil M16 abastecidos.
– 1 paquete de plástico conteniendo en su interior aproximadamente 3 kilogramos de hierba con características de marihuana.

Las camionetas, el armamento y demás objetos ilícitos fueron puestos a disposición del Ministerio Público Federal para realizar las investigaciones correspondientes.
Con estos resultados, el Gobierno Federal y el Gobierno del Estado reafirma su compromiso de salvaguardar el patrimonio y la integridad de la sociedad sinaloense al inhibir la circulación de armas y enervantes. Se invita a marcar oportunamente al 911 para cualquier emergencia y al 089 para realizar denuncias anónimas.